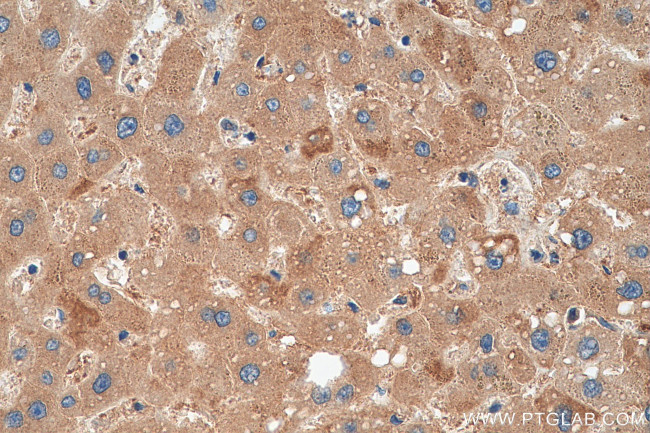
PPP2R1B Antibody in Immunohistochemistry (Paraffin) (IHC (P))

Search
Proteintech
PPP2R1B Polyclonal Antibody
{{$productOrderCtrl.translations['antibody.pdp.commerceCard.promotion.promotions']}}
{{$productOrderCtrl.translations['antibody.pdp.commerceCard.promotion.viewpromo']}}
{{$productOrderCtrl.translations['antibody.pdp.commerceCard.promotion.promocode']}}: {{promo.promoCode}} {{promo.promoTitle}} {{promo.promoDescription}}. {{$productOrderCtrl.translations['antibody.pdp.commerceCard.promotion.learnmore']}}
产品信息
12621-1-AP
种属反应
宿主/亚型
分类
类型
抗原
偶联物
形式
浓度
规格
纯化类型
保存液
内含物
保存条件
运输条件
产品详细信息
Immunogen sequence: ELGENLPIE DRETIIMNQI LPYIKELVSD TNQHVKSALA SVIMGLSTIL GKENTIEHLL PLFLAQLKDE CPDVRLNIIS NLDCVNEVIG IRQLSQSLLP AIVELAEDAK WRVRLAIIEY MPLLAGQLGV EFFDEKLNSL CMAWLVDHVY AIREAATNNL MKLVQKFGTE WAQNTIVPKV LVMANDPNYL HRMTTLFCIN ALSEACGQEI TTKQMLPIVL KMAGDQVANV RFNVAKSLQK IGPILDTNAL QGEVKPVLQK LGQDEDMDVK YFAQEAISVV AQRLRKLEFP VKDSGEPSVP RADKNHFPRP TVPGEDMGKG PVYQLRGDTR DTLAQLGIAE LVHFSQSTD (320-667 aa encoded by BC027596)
靶标信息
In eukaryotes, the phosphorylation and dephosphorylation of proteins on serine and threonine residues is an essential means of regulating a broad range of cellular functions, including division, homeostasis and apoptosis. A group of proteins that are intimately involved in this process are the protein phosphatases. In general, the protein phosphatase (PP) holoenzyme is a trimeric complex composed of a regulatory subunit, a variable subunit and a catalytic subunit. Four major families of protein phosphatase catalytic subunits have been identified, designated PP1, PP2A, PP2B (calcineurin) and PP2C. An additional protein phosphatase catalytic subunit, PPX (also known as PP4), is a putative member of a novel PP family. The PP2A family comprises subfamily members PP2A alpha and PP2A beta. The PP2A catalytic subunit associates with a variety of regulatory subunits. Regulatory subunits include PP2A-A alpha and -A beta, PP2A-B alpha and -B beta, PP2A-C alpha and -C beta, and PP2A-B56 alpha and -B56 beta.
仅用于科研。不用于诊断过程。未经明确授权不得转售。
生物信息学
蛋白别名: PP2A -AR1 beta; PP2A A beta; PP2A subunit A isoform PR65-beta; PP2A subunit A isoform R1-beta; PP2A, subunit A, PR65-beta isoform; PP2A, subunit A, R1-beta isoform; PP2A-A beta; PP2a-Abeta; protein phosphatase PP2A regulatory/structural subunit A isoform beta; PP2A-APR65 beta; PP2AA beta; protein phosphatase 2 (formerly 2A), regulatory subunit A (PR 65), beta isoform; protein phosphatase 2 (formerly 2A), regulatory subunit A, beta isoform; protein phosphatase 2, regulatory subunit A, beta; protein phosphatase 2, structural/regulatory subunit A, beta; Serine/threonine-protein phosphatase 2A 65 kDa regulatory subunit A beta isoform; unnamed protein product
基因别名: 2410091N08Rik; AI790395; PP2A-Abeta; PPP2R1B; PR65B
UniProt ID: (Human) P30154, (Mouse) Q7TNP2, (Rat) Q4QQT4
Entrez Gene ID: (Human) 5519, (Mouse) 73699, (Rat) 315648